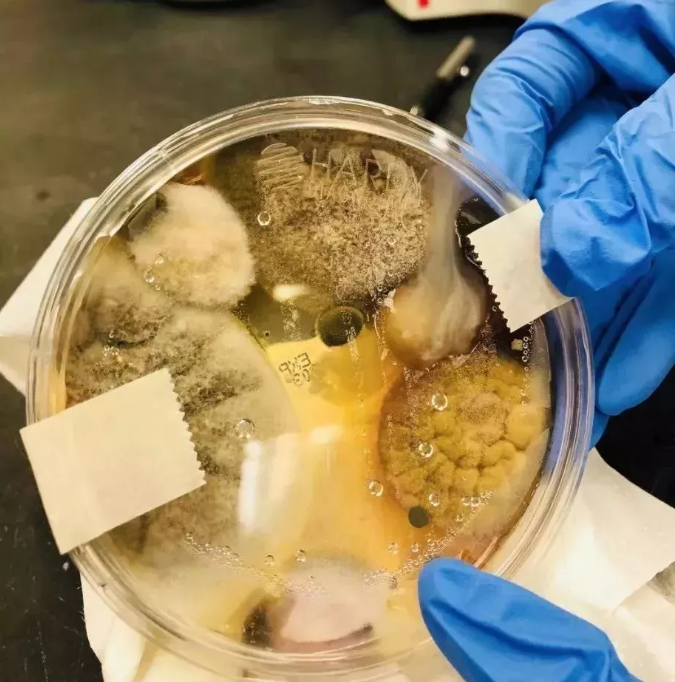

4.9
遠東SOGO敦化館宣布吹熄燈號!
台北再見!很抱歉我們要熄燈離開了!
全館萬件商品特價1折售,不賺錢只為清倉

遠東SOGO敦化館,自1994年開幕到2025年31年的時間,是引領東區時尚的重要地標,2025年12月14日,在悠揚樂音中於21:40畫下最完美篇章,遠東SOGO董事長黃晴雯特別獻花給陪到最後一刻最忠實的主顧客

SOGO敦化館暨全體員工再次感謝您31年來的支持與愛護
我們決定所有商品都將決定不計成本,一折清倉賠本處理!!
【日本Starchange香氛洗手露】在FACEBOOK渠道開通線上清倉銷售

原價NT$999每瓶 的Starchange香氛洗手露
買二瓶僅需NT$1098(每瓶低至$549!!!)
買三瓶僅需NT$1280(每瓶低至$426!!!)
買六瓶僅需NT$1480(每瓶低至$246!!!)
買九瓶僅需NT$1680(每瓶低至$186!!!)
現在購買,堪稱“史上最低價” !!

在台灣有超多藝人朋友都有使用我們Starchange香氛洗手露
藍心湄不止一次在網絡上推薦過Starchange香氛洗手露
純天然的有機配方,安全又健康,在忙碌的工作中有它的芳香放鬆心情,一天下來都不會覺得疲憊

芹仁夫妻也非常推薦Starchange香氛洗手露,這款三款手部清潔露的玫瑰味十分清新,男女都適用~

陳嘉樺大力推薦!
成分天然,敏弱肌也可以使用,溫和有效清潔及平衡所有膚質,誘人的桂花香味絕對會讓你愛不釋手!

柯以柔已經開團過超多次!每次賣到斷貨的產品,香氛洗手露選這款就對了!

詹姆士也是我們的愛用者!
不僅可以去除手部的細菌,除殘留手上的異味、細菌 (如 蒜、生肉海鮮)
殘留手上的色素 (如 蝦蟹、鮮豔果類)都可以通通去除! 真的大讚!

我們的研究人員做了一個試驗,把一個乾淨的底盤放進公共的空間裡,僅僅放進去了三分鐘,然後去做細菌培養,短短48小時培養皿裡瘋狂生長出來這些東西,而手是人們與外界接觸的主要部位,所以手上的細菌非常多。這些細菌往往會透過手部與身體其他部位的接觸乘虛而入,威脅到人們的健康!
正確洗手真的很有必要!

那我們應該怎麼正確洗手!清水洗沒用!5-10秒隨意沖洗沒用!


Starchange香氛洗手露特別添加IPMP抗菌成分,
20秒輕鬆告別細菌!洗後48小時有效抗菌!

日本研發石鹼清潔+高分子「潤澤鎖水屏障」配方,鎖住肌膚水分、預防肌膚越洗越乾燥
留住肌膚所需水分

採用法國某奈兒原廠工藝,使用同工原料調製
療癒香氛,清新不刺激的柔和清香

採用更天然有機成分(如花瓣或草藥等)。
Starchange 調香師親自到美國鄉村的茉莉花和玫瑰田提煉

100%日本製作,呵護您的健康














| ·購物流程 | |
|---|---|
|
| |
| ·退換貨流程 | |
|
● 收到商品之日起7天內,在不影響二次銷售的情況下,我們提供退/換貨服務;您可以聯繫網頁客服或郵件 提交退/換貨申請。
|